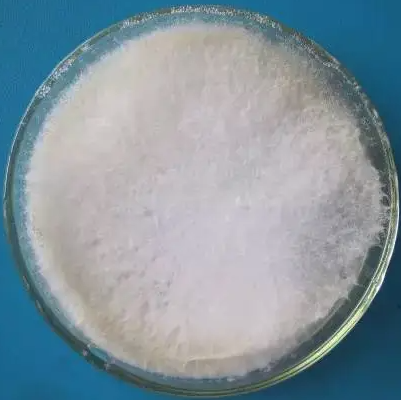
Nitratireductor Basaltis

网站主页
Nitratireductor Basaltis
Nitratireductor Basaltis
Nitratireductor Basaltis
Nitratireductor Basaltis
询价
1支
起订
北京 更新日期:2025-09-23
产品详情:
- 中文名称:
- Nitratireductor Basaltis
- 英文名称:
- Nitratireductor Basaltis
- 品牌:
- 微生物菌种查询网
- 产地:
- 中国
- 保存条件:
- 2-8度
- 纯度规格:
- 99.99%
- 产品类别:
- 化工
- 别名:
- KCTC 22119
- 用途:
- 科研
- 产品规格:
- 冻干粉/培养物
- 主要用途:
- 研究
- 是否危险化学品:
- 否
- 货号:
- Bio-79475
公司简介
北京百欧博伟生物技术有限公司(biobw)是北京的一家专业于生物技术的研究与广泛运用及推广的高科技公司,位于北京企业林立的丰台区造甲街,生物技术推广及运用早于2011年开始,成立公司于2013年一月。本公司主要提供色谱耗材、色谱仪器、固相萃取装置、化学试剂、样品瓶、氘灯、标准品、微生物技术、菌种保藏服务以及ATCC产品代理等产品及服务。
| 成立日期 | (13年) |
| 注册资本 | 50 万人民币 |
| 员工人数 | 10-50人 |
| 年营业额 | ¥ 300万-500万 |
| 经营模式 | 贸易,服务 |
| 主营行业 | 微生物学,细胞生物学,肼或胲的有机衍生物,生物技术服务,其他设备 |
Nitratireductor Basaltis相关厂家报价
-

- Pseudomonas Basaltis
- 北京百欧博伟生物技术有限公司
- 2025-09-03
- 询价